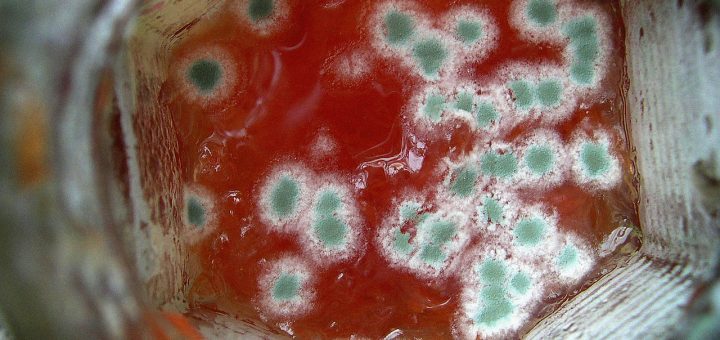

-
besserwohnen sagt:Danke - für den Mehrzahlhinweis - es darf auch Korpora in...
-
Melitta Fröch sagt:
-
Kathi Seibert sagt:
-
Lea Mühlich sagt:
-
Lisa Schmidt sagt:
- Bad Badezimmer Bauen Bauen mit Holz bauspardarlehen bausparen bausparer bausparprämie bausparvertrag Beton bett Diebstahl Eigenheimförderung Eigentum Einbrecher EInbruch Förderungen Garten Gartenpflege gesunder schlaf günstig wohnen HoHo Holz Holzboden Holzmöbel kinderzimmer klimaschonend Klimaschutz Kredit Matratzen Mietzinsbeihilfe nachhaltig Planung Rasen Revitalisierungen schlafen schlafstörung schlaftipps schlafzimmer Sonderförderungen Wohnbau Wohnbauföderung Wohnbeihilfe wohnungspreise Zusatzförderungen
Neueste Beiträge
Neueste Kommentare
- besserwohnen bei Warum sind Badezimmermöbel so teuer
- Melitta Fröch bei Warum sind Badezimmermöbel so teuer
- Kathi Seibert bei Sichere Fenster
- Lea Mühlich bei Sichere Fenster
- Lisa Schmidt bei Aufgaben der Hausverwaltungen
Archive
Kategorien
- Bad
- Banken & Finanzen
- Baufirmen
- Baumärkte
- Bausparkassen
- Baustoffe
- BesserBauen
- BesserGärtnern
- BesserLeben
- BesserPlanen
- BesserWohnen
- Einrichten
- Energie
- Facility Service
- Featured
- Förderungen
- Garten Center
- Gartengestaltung
- Genossenschaften
- Gesundheit
- Hausbau
- Hausverwaltungen
- Immobilienfonds
- Immobilienmakler
- Kinder-/Jugend
- Küchen
- Licht
- Mein Garten
- Möbel
- Professionisten
- Sanieren
- Schlafen
- Sicherheit
- Versicherungen
- Wärme
- Wohnklima
- Wohnraum
Mehr
CloudWords
Bad
Badezimmer
Bauen
Bauen mit Holz
bauspardarlehen
bausparen
bausparer
bausparprämie
bausparvertrag
Beton
bett
Diebstahl
Eigenheimförderung
Eigentum
Einbrecher
EInbruch
Förderungen
Garten
Gartenpflege
gesunder schlaf
günstig wohnen
HoHo
Holz
Holzboden
Holzmöbel
kinderzimmer
klimaschonend
Klimaschutz
Kredit
Matratzen
Mietzinsbeihilfe
nachhaltig
Planung
Rasen
Revitalisierungen
schlafen
schlafstörung
schlaftipps
schlafzimmer
Sonderförderungen
Wohnbau
Wohnbauföderung
Wohnbeihilfe
wohnungspreise
Zusatzförderungen